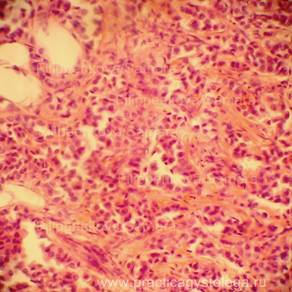
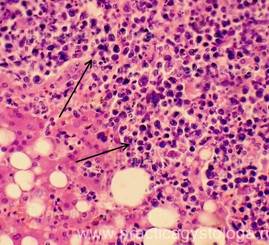
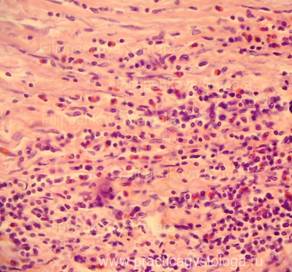
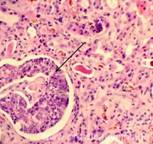

Полезное:
Как сделать разговор полезным и приятным
Как сделать объемную звезду своими руками
Как сделать то, что делать не хочется?
Как сделать погремушку
Как сделать так чтобы женщины сами знакомились с вами
Как сделать идею коммерческой
Как сделать хорошую растяжку ног?
Как сделать наш разум здоровым?
Как сделать, чтобы люди обманывали меньше
Вопрос 4. Как сделать так, чтобы вас уважали и ценили?
Как сделать лучше себе и другим людям
Как сделать свидание интересным?

Категории:
АрхитектураАстрономияБиологияГеографияГеологияИнформатикаИскусствоИсторияКулинарияКультураМаркетингМатематикаМедицинаМенеджментОхрана трудаПравоПроизводствоПсихологияРелигияСоциологияСпортТехникаФизикаФилософияХимияЭкологияЭкономикаЭлектроника

Центрального военного округа
|
|
443099, г. Самара, ул. Венцека, д. 48 тел. 339-97-80, 332-47-60
К «Заключению специалиста» № ХХХ 2011г.
Таблица № 9

| 
|
| Рис. 1, 2. Картина очагового острого гнойного межуточного миокардита: очаговая и очагово-диффузная инфильтрация стромы миокарда сегментоядерными нейтрофильными лейкоцитами в различной степени выраженности, лейкоциты как чётко контурирующиеся, так и в состоянии распада. Отдельные кардиомиоциты и мелкие их пучки в состоянии некроза. Окраска: гематоксилин-эозин. Увеличение х100, х250. | |

| Рис. 3. Септический метастатический очаг острого гнойного межуточного миокардита с колониями бактерий. В окружающем миокарде обилие сливающихся друг с другом мелких очагов умеренной-выраженной фуксинофилии цитоплазмы кардиомиоцитов в виде мелких их участков, окрашенных в красный цвет на жёлто-зелёном фоне. Окраска: ГОФП-метод (по Ли). Увеличение х100, х250. |
Специалист Филиппенкова Е.И.
Государственное учреждение здравоохранения
«САМАРСКОЕ ОБЛАСТНОЕ БЮРО СУДЕБНО-МЕДИЦИНСКОЙ ЭКСПЕРТИЗЫ»
К «Акту судебно-гистологического исследования» № 09-8/ ХХХ 2009 год
Таблица № 10

| 
|

| 
|
| Рис. 1-4. Метастазы аденокарциномы молочной железы в толще эпикарда и субэпикардиально в миокарде с полным его замещением. Труп женщины, 57 лет. Окраска: гематоксилин-эозин. Увеличение х100. Стеклопрепарат предоставлен врачом - судебно-медицинским экспертом судебно-гистологического отделения ГУЗ «Самарское ОБСМЭ» Ким С.В. | |

| 
|
| 
|
| Рис. 5-8. Аденокарцинома молочной железы (различные поля зрения микроскопа с различной степенью развития соединительнотканной стромы). Труп женщины, 57 лет (тот же). Окраска: гематоксилин-эозин. Увеличение х100. Стеклопрепарат предоставлен врачом - судебно-медицинским экспертом судебно-гистологического отделения ГУЗ «Самарское ОБСМЭ» Ким С.В. |
Легкие
1. Состояние кровенаполнения:
- диффузное или очаговое венозно-капиллярное полнокровие;
- неравномерное кровенаполнение с преобладанием венозно-капиллярного полнокровия, умеренного кровенаполнения или слабого кровенаполнения, спавшихся сосудов, сосудов с пустыми просветами.
2. Нарушения реологии крови: эритростазы, лейкостазы, разделение крови на плазму и форменные элементы, плазмостазы, фибриновые микротромбы, тромбы смешанные, белые, свежие, внутрипросветные, пристеночные, с признаками организации, реканализации.
3. Наличие в просветах сосудов на фоне эритроцитов небольших округлых оптических пустот, похожих на жировые эмболы (при травме). Возможны фрагменты тканей (тканевая эмболия при травме).
4. Дистония, спазм стенок сосудов. Изменения сосудистых стенок (дистония, спазм, картина острого гнойного или продуктивного васкулита, склероз).
5. Состояние лёгочной паренхимы:
- очаговая или диффузная эмфизема с указанием степени её выраженности, с образованием «птичьих шпор», указывающих на резко выраженную эмфизему при коротком агональном периоде,
- частичное спадение лёгочной ткани (дистелектазы) или полное её спадение (ателектазы);
- снижение или полное отсутствие воздушности лёгочной ткани при заполнении просветов альвеол воспалительным экссудатом, отёчной жидкостью, при наличии очагов казеозного некроза, пневмосклероза, разрастания атипичной ткани.
6. Состояние межальвеолярных перегородок: истончены, утолщены за счёт отёка, клеточной инфильтрации, склероза.

| 
|
| Рис. 1. Лёгкое. Очаг резко выраженной острой альвеолярной эмфиземы с истончением и разрывами большого количества межальвеолярных перегородок. Окраска: гематоксилин-эозин. Увеличение х100. | Рис. 2. Лёгкое. «Птичьи шпоры» (обрывки нескольких межальвеолярных перегородок, выступающих в просветы вздутой лёгочной ткани; стрелки). Окраска: гематоксилин-эозин. Увеличение х100, последующая вырезка фрагмента. |
7. Альвеолярный отёк: незначительный мелкоочаговый (единичные альвеолы содержат небольшое количество отёчной жидкости), мелкоочаговый, слабый, умеренный, выраженный мелко/средне/крупноочаговый, выраженный распространённый, массивный.
8. Кровоизлияния: мелко/средне/крупноочаговые, слабые, умеренные, выраженные, возможен их деструктивный характер, указывается цвет эритроцитов (насыщенно-красные, буровато-тёмно-красные), степень гемолиза эритроцитов, клеточная реакция (с лейкоцитозом, макрофагальной реакцией, пролиферацией фибробластов).
Очаги гемосидероза (скопления гемосидерофагов в просветах альвеол - при ХСН, хронической интоксикации).
9. Состояние бронхов: наличие склероза, воспаления, дистонии, спазма стенок, что находится в просветах (слущенный эпителий, эритроциты, гемосидерофаги, инородные частицы), состояние перибронхиальной ткани (при её воспалении).
10. Состояние лёгочной плевры ( не утолщена, без признаков склероза и воспаления; в состоянии умеренного или выраженного склероза и др.).
При умеренном и выраженном аутолизе уже нельзя отдифференцировать острую альвеолярную эмфизему и очаги гнилостной эмфиземы, нельзя говорить достоверно об альвеолярном отёке (может быть гнилостная жидкость).
Указывается, что на фоне аутолиза оценка срезов ограничена.
Пример№1.
ЛЁГКИЕ (2объекта) -на всей площади срезов одного из объектов представлен казеозный некроз с большим количеством угольного пигмента, единичными мелкими кальцинатами. В других срезах - также крупный очаг казеозного некроза, окружённый грубой соединительной тканью с выраженной очаговой круглоклеточной инфильтрацией, мелкими скоплениями гигантских многоядерных клеток Пирогова-Лангганса, без признаков перифокального воспаления. Специфическое воспаление, вызванное микобактерией туберкулёза, без признаков активности процесса.

| 
|
| Рис. 3, 4. Туберкулёз лёгких. Многоядерные гигантские клетки Пирогова-Лангганса (стрелки). Признаки активности специфического воспалительного процесса не прослеживаются. Окраска: гематоксилин и эозин. Увеличение х100 и х250. |
Пример№2.
ЛЁГКИЕ (4объекта, с бронхами, см. наличие бронхоспазма) -диффузное венозно-капиллярное полнокровие, эритростазы, в отдельных сосудах резко выраженный внутрисосудистый лейкоцитоз. Дистония, нерезкий спазм некоторых сосудов. Диапедезные микрогеморрагии, несколько мелкоочаговых экстра - и интраальвеолярных кровоизлияний насыщенно-красного цвета, с небольшим количеством лейкоцитов. Очаги острой альвеолярной эмфиземы различной степени выраженности и распространённости, с истончением и дефектами ряда межальвеолярных перегородок. Альвеолярный отёк в срезах 3-ёх объектов слабо выраженный очаговый (мелкоочаговый), в срезах 4-ого объекта - выраженный распространённый. В отдельных полях зрения в просветах альвеол слабо-умеренные скопления гемосидерофагов, выраженный периваскулярный отёк. В срезах представлены преимущественно крупные бронхи без признаков склероза и воспаления стенок, в состоянии лёгкой дистонии, с субтотальной и тотальной десквамацией мерцательного эпителия, признаками выраженной гиперсекреции слизи (большинство бокаловидных клеток значительно набухшее, с просветлением цитоплазмы), в просветах бронхов - пласты слущенного мерцательного эпителия, большое количество тяжей слизи, умеренное количество сегментоядерных нейтрофильных лейкоцитов, небольшое количество макрофагов. Лёгочная плевра в данных срезах не представлена. Картина острого гнойного эндобронхита.
| Рис. 5-7. Картина острого гнойного эндобронхита (стрелка) на фоне резко выраженной гиперсекреции слизи в виде значительного набухания, просветления бокаловидных клеток. В отдельных полях зрения выброс гроздевидных скоплений слизистого секрета в просвет бронхов. Окраска: гематоксилин и эозин. Увеличение х400. | 
|

| 
|
Пример№3.
ЛЁГКОЕ (1объект) -диффузное венозное и капиллярное полнокровие, диапедезные микрогеморрагии, очаговые слабые интра - и экстраальвеолярные кровоизлияния насыщенно-красного цвета, на фоне небольшого количества лейкоцитов и гемосидерофагов. Участки дистелектазов лёгочной ткани чередуются с очагами острой альвеолярной эмфиземы. Слабо выраженный очаговый альвеолярный отёк. В срезах представлены единичные небольшие бронхи без признаков склероза и воспаления стенок, с тотальной десквамацией мерцательного эпителия, в просветах - слущенный эпителий. В строме единичные мелкие очаги умеренной круглоклеточной инфильтрации. Лёгочная плевра в данных срезах не представлена.
Пример№4.
ЛЁГКИЕ (1объект гематоксилин-эозин, с множественными кровоизлияниями) -неравномерное кровенаполнение сосудов с преобладанием слабого их кровенаполнения, частично спавшихся сосудов, в ряде сосудов просветы растянуты, а также на фоне эритроцитарных масс в них небольшие округло-овальные оптические пустоты, похожие на жировые эмболы. На большей площади срезов выраженные очагово-диффузные кровоизлияния насыщенно-красного цвета, со слабо-умеренным лейкоцитозом на фоне зёрен формалинового пигмента. Участки дистелектазов лёгочной ткани чередуются с очагами выраженной острой альвеолярной эмфиземы, с дефектами ряда межальвеолярных перегородок. Незначительный мелкоочаговый альвеолярный отёк. Бронхи в срезах не прослеживаются. Лёгочная плевра без признаков склероза и воспаления, в состоянии слабо выраженного геморрагического пропитывания.
При окраске суданом-3 (1объект, 3среза) -в 10-ти полях зрения микроскопа при х56 увеличении (окуляр 7х, объектив 8х, на площади срезов 2 кв. см) обнаружено 3-4 жировых эмбола жёлто-оранжевого цвета, размерами более 8 мкм, обтурирующих просветы капилляров межальвеолярных перегородок, что соответствует очень слабой степени жировой эмболии малого круга кровообращения по Адкину В.И..
Пример№5.
ЛЁГКИЕ (4объекта) - неравномерное кровенаполнение сосудов с преобладанием венозно-капиллярного полнокровия, эритростазы, слабый и умеренный внутрисосудистый лейкоцитоз, пристеночное стояние лейкоцитов. На всей площади срезов лёгочная ткань безвоздушная: на фоне распространённого альвеолярного отёка просветы альвеол заполнены гнойно-фибринозным экссудатом. Межальвеолярные перегородки утолщены, разрыхлены, со слабо-умеренной лейкоцитарной инфильтрацией. Выраженный периваскулярный отёк. В срезах представлены единичные мелкие бронхи с заполнением их просветов гнойно-фибринозным экссудатом, стенки бронхов сливаются с картиной окружающей их пневмонии. Междолевая плевра значительно утолщена, разрыхлена, отёчна, со слабо-умеренной лейкоцитарной инфильтрацией. Лёгочная плевра также в состоянии некоторого отёка, с очаговым геморрагическим пропитыванием, в срезах 2-ух объектов со слабыми и слабо-умеренными наложениями фибрина с лейкоцитами. Гистологическое заключение: Выраженная картина гнойно-фибринозной пневмонии на фоне распространенного выраженного альвеолярного отёка. Слабо выраженная картина гнойно-фибринозного плеврита.

| 
|
| Рис. 8, 9. Выраженная картина гнойно-фибринозной пневмонии на фоне распространенного выраженного альвеолярного отёка. Окраска: гематоксилин и эозин. Увеличение х250. |
Пример№6.
ЛЁГКИЕ (2объекта, судан-3) -
В ОДНИХ СРЕЗАХ -в 10-ти полях зрения микроскопа при х56 увеличении (окуляр 7х, объектив 8х, на площади срезов 2 кв. см) обнаружено до 170-180 жировых эмболов жёлто-оранжевого цвета, размерами более 8 мкм, расположенных в капиллярах межальвеолярных перегородок (большая их часть обтурирующего типа), артерий и вен различного калибра, что соответствует выраженной степени жировой эмболии малого круга кровообращения по Адкину В.И..
В ДРУГИХ СРЕЗАХ -в 10-ти полях зрения микроскопа при х56 увеличении (окуляр 7х, объектив 8х, на площади срезов 2 кв. см) обнаружено до 200-210 жировых эмболов жёлто-оранжевого цвета, размерами более 8 мкм, обтурирующих капилляры межальвеолярных перегородок, артерий и вен различного калибра, что соответствует переходу выраженной степени жировой эмболии малого круга кровообращения в очень выраженную степень по Адкину В.И..

| 
|
| Рис. 10, 11. Обтурирующие жировые эмболы жёлто-оранжевого цвета в просветах капилляров межальвеолярных перегородок, артерий и вен (стрелки). Окраска: судан-3. Увеличение х250. | |

| Рис. 12. В просветах сосудов лёгких на фоне эритроцитов и внутрисосудистого лейкоцитоза наличие округло-овальных оптических пустот, похожих на жировые эмболы (стрелка). Окраска: гематоксилин и эозин. Увеличение х250. |
Наличие жировых эмболов в просветах сосудов лёгких можно предположить по наличию на фоне эритроцитов и других элементов крови в просветах сосудов небольших округло-овальных оптических пустот.

| 
|
| Рис. 1. Крупноочаговый выраженный альвеолярный отёк. Группы альвеол с заполнением просветов гемосидерофагами. Окраска: гематоксилин и эозин. Увеличение х100. | Рис. 2. Фрагмент участка дистелектаза лёгочной ткани. Окраска: гематоксилин и эозин. Увеличение х100. |

| 
|
| Рис. 3. В просветах отдельных сосудов видны обтурирующие жировые эмболы в виде колбасовидных однородных оранжево-жёлтых капель размерами более 8 мкм. На площади срезов 2 кв. см обнаружено до 45-50 подобных жировых эмболов (стрелка). Окраска: судан-3. Увеличение х250. | Рис. 4. На фоне внутрисосудистого лейкоцитоза и мелких фибриновых тромбов в отдельных сосудах лёгких обнаружены группы по 2-3 округло-овальные оптические пустоты, похожие на жировые капли (стрелка). Окраска: гематоксилин и эозин. Увеличение х250. |
Ткань лёгкого с выраженным геморрагическим синдромом, картиной очаговой острой гнойной пневмонии, наличием инородных частиц в просветах бронхов небольшого калибра.
Окраска: гематоксилин и эозин. Увеличение х100 и х250.

| 
|
| Рис. 1. В просвете небольшого бронха на фоне эритроцитов, сегментоядерных нейтрофильных лейкоцитов, отёчной жидкости единичное скелетное мышечное волокно с частично сохранившейся поперечной исчерченностью (стрелка). | Рис. 2. Небольшой бронх с довольно большим количеством отёчной жидкости, насыщенно-красных эритроцитарных масс, небольшим количеством сегментоядерных лейкоцитов в просвете. |

| 
|
| Рис. 3. В просвете одного бронха среднего сечения на фоне отёчной жидкости, эритроцитов, сегментоядерных лейкоцитов инородное тело, похожее на микрофрагмент плетёной нити (стрелка). | Рис. 4. В просвете одного бронха среднего сечения на фоне отёчной жидкости, геморрагического синдрома и гнойного экссудата наличие мелких инородных серо-чёрных частиц, похожих на копоть (стрелки). |

| 
|

| 
|
| Рис. 1-4. Межальвеолярные перегородки утолщены, с инфильтрацией макрофагами, гистиоцитами, лимфоцитами, сосуды в них полнокровны, в отдельных сосудах наличие криптококков. В просветах ряда альвеол на фоне отёчной жидкости видны скопления криптококков различной степени зрелости. Группы макрофагов с заполнением цитоплазмы криптококками. Картина гематогенной диссеминации криптококка (фунгемии, рис. 3, стрелки). В ткани значительно утолщенной лёгочной плевры на фоне её склероза, отёка, продуктивного воспаления наличие гигантских многоядерных макрофагов по типу клеток Пирогова-Лангганса и клеток инородных тел (рис. 4, стрелка). Окраска: гематоксилин и эозин. Увеличение х100, х250, х400. |

| 
|

| 
|
| Рис. 1-4. Лёгкие ВИЧ - инфицированной женщины, 29 лет. Стенки большинства сосудов утолщены за счёт выраженной полиморфноклеточной инфильтрации с преобладанием продуктивного компонента (как бы одеты в клеточные муфты). В просветах ряда сосудов видно большое количество белесоватых округлых дрожжеподобных элементов (рис. 2, стрелка). Практически во всех просветах альвеол, несколько отступя от стенки альвеолы (местами видны тонкие ограничивающие мембраны), расположены однообразные ячеистые розовые массы, а также отдельные двуядерные структуры). Вокруг зрелых пневмоцист сосредоточено большое количество молодых форм (трофозоидов), имеющих лабильные очертания. По мере созревания внутриклеточные тельца заполняют зрелые цисты, их оболочка разрывается, внутриклеточные тельца выталкиваются в окружающие ткани, превращаясь в трофозоиды. Материнские клетки приобретают чашевидные или полулунные очертания, постепенно дегенерируют (рис. 3, стрелки). Межальвеолярные перегородки умеренно и значительно утолщены за счёт инфильтрации мононуклеарами (рис. 4, стрелки). В строме видны небольшие и средней величины очаги выраженного продуктивного воспаления (рис. 4, стрелки). Окраска: гематоксилин-эозин. Увеличение х250, х400. |

| 
|
| Рис. 1-4. В ткани лёгкого скопления актиномицет (стрелки; свидетельство резкого снижения иммунитета). Актиномицеты - это грамположительные высшие бактерии, имеющие ветвистое строение, чувствительные к антибиотикам и способные вызывать нейтрофильный воспалительный ответ в содружестве с другими бактериями. Лёгкие с картиной актиномикотической пневмонии. Окраска: гематоксилин-эозин. х250 и х400. | |

| 
|

| 
|
| Рис. 1-4. Лёгкие новорожденного. Пневмопатия: дис - и ателектазы, гиалиновые мембраны. Очаговое умеренное венозно-капиллярное полнокровие. Лёгочная ткань с незначительной воздушностью за счёт преобладания частичного и полного её спадения. Межальвеолярные перегородки толстые, в ряде из них различима слабо выраженная лейкоцитарная инфильтрация. В большом количестве альвеол по ходу межальвеолярных перегородок отложения плотных эозинофильных бесструктурных масс (гиалиновые мембраны, стрелки). Бронхи с тотальной десквамацией мерцательного эпителия, в состоянии спадения различной степени выраженности, часть просветов бронхов заполнена пластами слущенного эпителия. Окраска: гематоксилин-эозин. Увеличение х100 и х250. | |

| 
|

| 
|
| Рис. 1-4. Язычковые, булавовидные, по типу «петушиных гребней» полипы стенки бронха (стрелки) на фоне хронического бронхита. Окраска: гематоксилин-эозин. Увеличение х100 и х250. | |

| 
|

| 
|
| Рис. 1, 2. Лёгочная миграция личинок аскариды (стрелки) с перифокальной реактивной очаговой острой гнойной пневмонией. В гнойном экссудате в просвете альвеол бледно-розовые округло-овальные включения, похожие на клубки червеобразных структур (стрелки). Вокруг личинок аскариды неравномерный ободок просветления в экссудате (показатель движения личинки аскариды). Окраска: гематоксилин и эозин. Увеличение х250, х400. |
Печень
1. Состояние кровенаполнения:
- синусоидных капилляров;
- центральных вен;
- вен портальных трактов.
2. Нарушения реологии крови: эритростазы, лейкостазы, разделение крови на плазму и форменные элементы, плазмостазы, микротромбы, тромбы.
3. Состояние стенок вышеуказанных сосудов: склероз, плазматическое пропитывание, гиалиноз, некроз, васкулит острый гнойный, продуктивный или полиморфноклеточный. Наличие периваскулярного склероза вокруг центральных вен (перивенулярный склероз, характерно для алкогольной печени).

| Рис. 1. Печень. Перивенулярный склероз - слабо выраженное циркулярное разрастание фиброзной ткани вокруг центральной вены (стрелка). Около 1/8 гепатоцитов подверглось мелко -, средне - и крупнокапельной жировой дистрофии. В строме дольки по ходу синусоидных капилляров мелкие очажки слабо выраженной полиморфноклеточной инфильтрации (лимфогистиоцитарная инфильтрация + сегментоядерные нейтрофильные лейкоциты). Окраска: гематоксилин-эозин. Увеличение х250. |
4. Расширение (отёк) перисинусоидальных пространств Диссе.

| 
|
| Рис. 2-5. На фоне неравномерно выраженного капиллярно-венозного полнокровия с эритростазами неравномерное расширение (отёк) перисинусоидальных пространств Диссе, варьирующее от слабого до выраженного (стрелки). Окраска: гематоксилин-эозин. Увеличение х250. | |

| 
|
5. Балочно-радиарное строение печёночных долек:
- сохранено, чёткое, прослеживается;
- стёрто при наличии умеренного, выраженного жирового гепатоза, мелкоочаговых некрозов;
- нарушено при наличии мостовидных (перекидывающихся с дольки на дольку) и мультилобулярных некрозов, картины неполного септального, моно - и мультилобулярного, смешанного цирроза печени, крупных очагов фиброза.
6. Наличие клеток Краевского (гепатоциты с признаками мобилизации гликогена, значительно набухшие, с просветлённой цитоплазмой, полигональной формы, расположены компактно, в виде «булыжной мостовой»).
7. Дистрофические изменения гепатоцитов: белковая зернистая дистрофия, вакуольная дистрофия, гидропическая дистрофия, жировая дистрофия (диссеминированная, мелкоочаговая, средне - и крупноочаговая, умеренная и выраженная диффузная, субтотальная, тотальная).

| 
|
| Рис. 6, 7. Печень. Очаги выраженной гидропической дистрофии гепатоцитов (стрелки) в сочетании с крупнокапельной жировой дистрофией печёночных клеток. Окраска: гематоксилин-эозин. Увеличение х250. |
8. Некрозы гепатоцитов (мелких групп клеток, мелко/среднеочаговые в пределах дольки, мостовидные - перекидывающиеся с дольки на дольку, мультилобулярные - захватывающие несколько смежных долек).
9. Состояние портальных трактов (не расширены, без признаков склероза и воспаления; с отёком стромы, расширены за счёт склероза, со слабой, умеренной, выраженной очаговой или диффузной лейкоцитарной или лимфогистиоцитарной инфильтрацией с единичными сегментоядерными лейкоцитами; отхождение от склерозированных портальных трактов фиброзных тяжей различной толщины и протяжённости).
10. Наличие дефектов ткани (при травме).
11. Наличие разрастания атипичной ткани.

| 
|
| Рис. 8, 9. Метастазы плоскоклеточного рака лёгкого в ткань печени (стрелки). Сохранившаяся печёночная ткань сдавлена, гепатоциты деформированы. Окраска: гематоксилин-эозин. Увеличение х100. |
13. Состояние капсулы печени.
Пример№1.
ПЕЧЕНЬ (1объект) -в срезах неравномерный слабый аутолиз. Неравномерное кровенаполнение синусоидных капилляров, варьирующее от слабого и слабо-умеренного кровенаполнения их до очагового полнокровия. Полнокровие центральных вен и вен портальных трактов. Балочно-радиарное строение долек начинает стираться на фоне умеренно выраженной очагово-диффузной крупнокапельной жировой дистрофии гепатоцитов. Остальные печёночные клетки в состоянии умеренной мелкокапельной жировой дистрофии. Портальные тракты практически не расширены, в строме ряда из них очаговая умеренная лимфогистиоцитарная инфильтрация с единичными сегментоядерными лейкоцитами. Капсула печени в данных срезах не представлена. Гистологическое заключение: Умеренно выраженный жировой гепатоз. Слабо-умеренная картина хронического персистирующего гепатита.
Рис.10-17. Жировой гепатоз различной степени выраженности, в отдельных срезах с очаговой вакуольной, гидропической дистрофией гепатоцитов и очагами хронического воспаления, тельцами Маллори (алкогольный гиалин, рис. 17, стрелка). Окраска: гематоксилин и эозин. Увеличение х100, х250 и х400. Одна фотография в чёрно-белом варианте.

| 
|

| 
|

| 
|

| 
|
Пример№2.
ПЕЧЕНЬ (1объект) -в срезах диффузный слабо выраженный аутолиз. Очагово-диффузное выраженное полнокровие синусоидных капилляров. Полнокровие центральных вен и вен портальных трактов. Балочно-радиарное строение долек чёткое. Цитоплазма гепатоцитов зернистого вида, без признаков жировой дистрофии. Портальные тракты не расширены, в строме единичных из них очень слабая лимфогистиоцитарная инфильтрация, единичные мелкие круглоклеточные инфильтраты обнаружены в строме долек. Начальный склероз стенок артерий триад. Капсула печени в данных срезах не представлена.
Гистологическое заключение: Очень слабо выраженные признаки хронического персистирующего гепатита.
Пример№3.
ПЕЧЕНЬ (2объекта) -слабое кровенаполнение синусоидных капилляров (капилляры сдавлены дистрофически изменёнными гепатоцитами). Единичные мелкоочаговые диапедезно-деструктивные кровоизлияния насыщенно-красного цвета, с небольшим количеством лейкоцитов. Просветы центральных вен преимущественно пустые. Полнокровие ряда вен портальных трактов. Балочно-радиарное строение долек стёрто на фоне выраженной очагово-диффузной крупнокапельной жировой дистрофии гепатоцитов и выраженной их гидропической дистрофии. Небольшие группы сохранившихся печёночных клеток с признаками деления ядерного материала. Отдельные портальные тракты слабо расширены, в их строме диффузная слабо-умеренная лимфогистиоцитарная инфильтрация, единичные сегментоядерные лейкоциты. Капсула печени не утолщена. Гистологическое заключение: Выраженный жировой гепатоз с выраженной очаговой гидропической дистрофией гепатоцитов. Слабо-умеренная картина хронического персистирующего гепатита.

| Рис.18. Печень с сочетанием выраженной очагово-диффузной крупнокапельной жировой дистрофией гепатоцитов и гидропической дистрофии. Окраска: гематоксилин и эозин. Увеличение х250. |
Пример№4.
ПЕЧЕНЬ (1объект) -в срезах неравномерный начальный, слабый аутолиз. Слабое и слабо-умеренное кровенаполнение синусоидных капилляров (капилляры сдавлены дистрофически изменёнными гепатоцитами). Различное кровенаполнение центральных вен (от пустых просветов до умеренного полнокровия). Полнокровие ряда вен портальных трактов. Балочно-радиарное строение долек стирается на фоне умеренно выраженной очагово-диффузной мелко/средне/крупнокапельной жировой дистрофии гепатоцитов. Мелкие группы печёночных клеток в состоянии вакуольной, гидропической дистрофии. Отдельные портальные тракты незначительно расширены, в их строме слабая и слабо-умеренная очаговая лимфогистиоцитарная инфильтрация. Капсула печени в данных срезах не представлена.
Гистологическое заключение: Умеренно выраженный жировой гепатоз. Слабо выраженные признаки хронического персистирующего гепатита.
Пример№5.
ПЕЧЕНЬ (1объект) -очагово-диффузное полнокровие синусоидных капилляров. Слабо выраженное расширение перисинусоидальных пространств Диссе. Полнокровие центральных вен и вен портальных трактов, в отдельных сосудах разделение крови на плазму и форменные элементы. Балочно-радиарное строение долек чёткое. Гепатоциты преимущественно значительно набухшие, в состоянии выраженной белковой зернистой дистрофии. Диффузно расположены множественные клетки Краевского. Портальные тракты не расширены, без признаков склероза и воспаления стромы. Капсула печени в данных срезах не представлена.
Клетки Краевского -гепатоциты с признаками мобилизации гликогена,печёночные клетки значительно набухшие, с выраженным просветлением цитоплазмы, полигональной формы, расположены компактно, в виде «булыжной мостовой».
| Рис.19-21. Клетки Краевского в виде скоплений различной величины (стрелки). Окраска: гематоксилин и эозин. Увеличение: х250 и х400. | 
|

| 
|
Пример№6.
ПЕЧЕНЬ (1объект) - кровенаполнение синусоидных капилляров варьирует от слабого кровенаполнения до очагового умеренного их полнокровия. В зоне фиброзных тяжей умеренное полнокровие ряда небольших сосудов. Балочно-радиарное строение печёночных долек нарушено за счёт умеренного разрастания тяжей грубой фиброзной ткани различной толщины и протяжённости, со слабо выраженной очаговой круглоклеточной инфильтрацией, исходящих из склерозированных портальных трактов и зон перивенулярного склероза (вокруг центральных вен), охватывающих небольшие группы гепатоцитов в пределах одной печёночной дольки и крупные группы гепатоцитов в пределах нескольких смежных печёночных долек. Гепатоциты в состоянии выраженной белковой зернистой дистрофии, часть из них деформирована, в состоянии атрофии, с признаками регенерации в виде деления ядер и самих клеток. До 2-3% печёночных клеток подверглось крупнокапельному ожирению.
Гистологическое заключение: Картина мономультилобулярного цирроза печени.
Пример№7.
ПЕЧЕНЬ (2объекта) -кровенаполнение синусоидных капилляров варьирует от слабого и слабо-умеренного кровенаполнения до очагового умеренного полнокровия. Балочно-радиарное строение печёночных долек на крупных участках срезов нарушено за счёт наличия крупных очагов разрастания атипичной ткани с гистологической картиной гепатоцеллюлярного рака. Мелкие очаги опухолевой ткани и небольшие группы гепатоцитов в состоянии некроза со слабо выраженным реактивным лейкоцитозом. Видны небольшие сосуды с распространением опухолевых клеток по ходу их стенок и с наличием опухолевых конгломератов в просветах (гематогенная диссеминация опухоли). Сохранившиеся гепатоциты в состоянии выраженной и резко выраженной белковой зернистой дистрофии, с признаками гипотрофии, атрофии, деформации. Небольшие очаги гидропической дистрофии гепатоцитов. До 15-20% печёночных клеток подверглось мелко- и крупнокапельному ожирению. Умеренное количество гепатоцитов с признаками их регенерации в виде деления их ядер и самих клеток. Портальные тракты слабо расширены за счёт склероза, с очаговой слабо выраженной лимфогистиоцитарной инфильтрацией. Капсула печени с неравномерным слабым и умеренным склерозом, на её поверхности слабо выраженные тонкие полосовидные наложения рыхлого фибрина. Гистологическое заключение: Гепатоцеллюлярный рак. Картина хронического персистирующего гепатита. Признаки фибринозного перитонита.

|
|

| 
|
| Рис.22-25. Гепатоцеллюлярный рак (стрелки) с мелкими очагами распада (рис. 22, стрелка), гематогенным распространением и распространением опухолевых клеток по ходу сосудистых стенок (рис. 25, стрелка). Окраска: гематоксилин и эозин. Увеличение х100 и х250. |

| Рис. 1. Картина неполного септального цирроза печени: портальные тракты слабо-умеренно расширены, в их строме умеренная лимфогистиоцитарная инфильтрация, от трактов отходят неширокие фиброзные тяжи различной распространённости, склонные к слиянию друг с другом и охвату небольших групп гепатоцитов. Окраска: гематоксилин и эозин. Увеличение х100. |

| Рис. 2. Фрагмент кавернозной гемангиомы печени (стрелки), отдельные синусоидоподобные полости заполнены кровью, некоторые с элементами тромбоза. Окраска: гематоксилин и эозин. Увеличение х100. |

| Рис. 3. В окружности кавернозной гемангиомы и вызванных ею изменений в ткани печени обнаружены мелкие гранулёмы без некроза, с наличием 1-2 гигантских многоядерных макрофага (стрелка). Окраска: гематоксилин и эозин. Увеличение х250. |

| 
|
| Рис. 1. Фрагмент небольшой очаговой холангиогенной аденомы в ткани печени. Окраска: гематоксилин и эозин. Увеличение х100. | Рис. 2. Фрагмент очаговой каверзной гемангиомы с полнокровными синусоидоподобными полостями (стрелки). Выраженные признаки регенерации гепатоцитов в виде деления их ядер и самих клеток. Окраска: гематоксилин и эозин. Увеличение х100. |

| 
|
| Рис. 3, 4. Крупный участок ткани печени с выраженным отложением гомогенного аморфного бледно-розового вещества между печёночными балками (стрелки). Последние истончены в различной степени выраженности, вплоть до резко выраженной их атрофии. Окраска: гематоксилин и эозин. Увеличение х100 и х250. |

| 
|

| 
|
| Рис. 1-4. Очаги криптококкоза в печени, замещающие гепатоциты. Криптококки различной степени зрелости (стрелки). В ряде полей зрения видна гематогенная диссеминация гриба (отдельные криптококки и их скопления в синусоидных капиллярах). Гепатоциты набухшие, в состоянии выраженной белковой зернистой дистрофии, мелко- и крупнокапельной жировой дистрофии. В цитоплазма ряда макрофагов «нафарширована» грибковыми элементами (стрелки). Окраска: гематоксилин и эозин. Увеличение х250 и х400. |

| 
|

| 
|
| Рис. 1-4. Амилоидоз печени. Отложение патологического белка амилоида в строме печёночных долек по ходу синусоидных капилляров, в строме портальных трактов, по ходу сосудистых стенок (стрелки). Сохранившиеся гепатоциты в состоянии выраженной белковой зернистой дистрофии, в состоянии гипотрофии и атрофии. Окраска: Конго красный. Увеличение х100 и х250. |

| 
| |

| 
| |
| Рис. 1-4. Острый эозинофильный межуточный гепатит. Выраженная очагово-диффузная лейкоцитарная инфильтрация стромы с преобладанием эозинофилов (стрелки). Резко выраженное очагово-диффузное капиллярно-венозное полнокровие с эритростазами, диапедезными микрогеморрагиями. Часть гепатоцитов в состоянии некробиоза-некроза. Сохранившиеся печёночные клетки в состоянии выраженной белковой зернистой дистрофии, мелко-, средне- и крупнокапельной жировой дистрофии. Окраска: гематоксилин и эозин. Увеличение х250 и х400. | ||

| 
| |
| Рис. 1-4. Печень. Липофусциноз цитоплазмы гепатоцитов в виде наличия золотисто-жёлтых зёрен (стрелки). Окраска: гематоксилин-эозин. Увеличение х250 и х400. | ||

| 
| |

| 
|
| Рис. 1-4. «Мускатная» печень. Резко выраженное центролобулярное полнокровие синусоидных капилляров с эритростазами, диапедезными кровоизлияниями, гепатоциты значительно истончены, атрофичны (стрелки). Выраженное полнокровие центральных вен с эритростазами. На периферии долек умеренное кровенаполнение синусоидных капилляров, гепатоциты обычных размеров, с цитоплазмой зернистого вида. Окраска: гематоксилин-эозин. Увеличение х100 и х250. | |

| 
|

|
| ||
| Рис. 1-5. Печень. Рис. 1, 2 - соединительнотканная капсула с полиморфноклеточным воспалением, эозинофилией, ограничивающая очаг эхинококкоза. Рис. 3-5 - элементы эхинококка (стрелки), один из них (рис.5) частично некротизирован. Окраска: гематоксилин-эозин. Увеличение х100, х250 и х400. | |||

| 
| 
| |

| 
|

| 
|
| Рис. 1-8. Печень. ВИЧ - инфицированный мужчина, 25 лет. Очагово-диффузный гемосидероз (стрелки). Скопления зёрен буро-коричневого гемосидерина в толще ткани, цитоплазме макрофагов (клеток Купфера). Окраска: гематоксилин-эозин. Увеличение х100, х250, х400. | |

| 
|

| 
|

| 
|
| Рис. 1-4. Печень. Туберкулёзные гранулёмы (как без признаков воспаления, «старые», так и с полиморфноклеточным воспалением) с гигантскими многоядерными клетками Пирогова-Лангганса (стрелки). Окраска: гематоксилин-эозин. Увеличение х250. | |

| 
|

| 
|
| Рис. 1-4. Врождённый фиброз печени с выраженной картиной холестаза (последний отмечен стрелками). Окраска: гематоксилин-эозин. Увеличение х250. | |

| 
|

| 
|
| Рис. 1-4. Печень плода с сохранившейся функцией кроветворения: наличие очагов миелоидного ростка, оксифильных проэритроцитов (рис. 2, стрелки), мегакариоцитов (рис. 3, 4, стрелки). Окраска: гематоксилин-эозин. Увеличение х250 и х400. | |

| 
|
Почки
1. Состояние кровенаполнения коркового и мозгового вещества (диффузное или очаговое венозно-капиллярное полнокровие, чередование участков слабого кровенаполнения и очагов венозно-капиллярного полнокровия, преобладание слабого кровенаполнения).
2. Нарушения реологических свойств крови (эритростазы, внутрисосудистый лейкоцитоз, пристеночное стояние лейкоцитов, разделение крови на плазму и форменные элементы, плазмостазы, тромбоз сосудов).
3. Состояние стенок почечных артерий, артериол (утолщены за счёт склероза, гиалиноза, плазматического пропитывания, с явлением некроза, острого гнойного или продуктивного васкулита).
4. Состояние интерстиция (очаговый или диффузный слабый, умеренный, выраженный отёк интерстиция).

| Рис. 1. На фоне выраженного диффузного капиллярно-венозного полнокровия коркового вещества с эритростазами выраженный диффузный отёк его интерстиция (стрелки). Окраска: гематоксилин и эозин. Увеличение х250. |
5. Состояние почечных клубочков (строение их сохранено, клубочки в состоянии атрофии, склероза, гиалиноза, с наличием склероза капсулы Шумлянского-Боумена различной степени выраженности, с наличием в просвете капсулы Шумлянского гомогенной бледно-розовой жидкости и слабо-зернистых бледно-розовых масс).

|
| 
| 
|
| Рис. 2, 3. Гнойное расплавление почечных клубочков (стрелки). Острый гнойный гломерулонефрит. Окраска: гематоксилин и эозин. Увеличение х400. | Рис. 4, 5. «Лапчатый» клубочек при хроническом гломерулонефрите (стрелка). Заполнение капсулы Шумлянского-Боумена бледно-розовым гомогенным содержимым (стрелка). Окраска: гематоксилин и эозин. Увеличение х400. |
6. Наличие очагов нефросклероза, продуктивного или острого воспаления (мелко/средне/крупноочаговые, выраженные диффузные, сетчатого типа, тотальные).

| 
| ||
| Рис. 6-11. Выраженный крупноочаговый нефросклероз с продуктивным воспалением, обилие густо расположенных склерозированных почечных клубочков, склероз сосудистых стенок (стрелки). Окраска: гематоксилин и эозин. Увеличение х100, х250, х400. | |||

| 
| 
| 
|
7. Наличие очагов некроза почечной ткани (некронефроза), реактивная клеточная реакция, степень её выраженности.

| 
|

| 
|
| Рис. 12-15. Фрагменты обширных очагов некронефроза (крупные группы канальцев в состоянии некроза), с преобладанием выраженной лейкоцитарной инфильтрации. Окраска: гематоксилин и эозин. Увеличение х250. |
7. Состояние эпителия почечных канальцев:
- белковая зернистая дистрофия различной степени выраженности;
- вакуольная (мелко/средне/крупновакуольная) дистрофия (по ходу базальной мембраны канальцев или во всём объёме цитоплазмы эпителиоцитов расположены белесоватые вакуоли);
- гиалиново-капельная дистрофия различной степени выраженности;
- гидропическая, водяночная дистрофия различной степени выраженности, вплоть до максимальной степени её выраженности - баллонной дистрофии (эпителиоциты значительно набухшие, с выраженным просветлением цитоплазмы);
- некробиозы-некрозы отдельных эпителиоцитов, групп клеток, целых канальцев (ядра не видны, границы между клетками не прослеживаются).

| Рис. 16. Выраженная белковая зернистая дистрофия эпителия почечных канальцев, некробиозы-некрозы отдельных эпителиоцитов и мелких групп клеток, слабо-умеренные признаки атрофии канальцев в виде снижения высоты эпителия, расширения просветов канальцев. В просветах канальцев - бледно-розовые слабо-зернистые массы. Окраска: гематоксилин и эозин. Увеличение х250. |

| 
|
| Рис. 17, 18. Вакуольная, гидропическая дистрофия эпителия почечных канальцев в большей части случаев различима на фоне слабого, умеренного и даже выраженного аутолиза (стрелки). Окраска: гематоксилин и эозин. Увеличение х250. |

| 
|
| Рис. 19, 20. Гиалиново-капельная дистрофия эпителия почечных канальцев (стрелки) с некробиозами-некрозами отдельных эпителиоцитов, групп клеток и целых канальцев. Окраска: гематоксилин и эозин. Увеличение х400. |

| 
|

| 
|

| 
|
| Рис. 21-26. Выраженная гидропическая дистрофия (близко к баллонной) эпителия почечных канальцев (стрелки), некробиозы-некрозы отдельных эпителиоцитов и групп клеток. Сочетание выраженного крупноочагового продуктивного воспаления ткани почки и крупных очагов выраженной гидропической дистрофии эпителия канальцев. Окраска: гематоксилин и эозин. Увеличение х250 и х400. |
8. Наличие канальцев в состоянии нефрокальциноза (эпителиоциты инкрустированы солями кальция или в просветах канальцев наличие мелких кальцинатов) - чаще всего имеет постнекротический генез, также может быть проявлением гиперкальциемии.
Нефрокальциноз -
1. инкрустация эпителиоцитов канальцев солями кальция, чаще всего исход некроза эпителиоцитов;
2. в просветах канальцев видны включения мелких кальцинатов (характерно для гиперкальциемии);
3. смешанный вариант.

| 
|

| 
|
| Рис. 27-30. Группы канальцев в состоянии нефрокальциноза (стрелки). Окраска: гематоксилин и эозин. Увеличение х100, х250, х400. |
9. БИН-симптом (базальная инкрустация нефротелия) -при наличии внутрисосудистого гемолиза эритроцитов до момента физиологической смены эпителиоцитов канальцев по ходу базальной мембраны расположены пылевидные или в виде гранул отложения золотисто-жёлтого или буро-коричневого пигмента.
| Рис. 31-33. БИН-симптом в виде пылевидного золотисто-жёлтого и в виде буро-коричневых гранул отложения гемоглобинового пигмента по ходу базальной мембраны почечных канальцев (стрелки). В большинстве канальцев - вакуольная дистрофия эпителия различной степени выраженности. Окраска: гематоксилин и эозин. Увеличение х250 и х400. | 
|

| 
|
10. Признаки атрофии канальцев в виде истончения эпителия, расширения просветов (вплоть до очагов «щитовидной почки»).

| 
|
| Рис. 35, 36. «Щитовидная почка» - почечные канальцы в состоянии резко выраженной атрофии, эпителий значительно истончён, просветы их кистозно расширены, заполнены гомогенным розовым коллоидоподобным содержимым (стрелки). Окраска: гематоксилин и эозин. Увеличение х250 |
11. Содержимое просветов канальцев (белковые массы, гиалиновые цилиндры, пигментные шлаки буро-коричневатого цвета, буро-красноватые зёрна миоглобина, слущенные эпителиоциты, свежие и выщелоченные эритроциты, кристаллы оксалатов при оксалатурии или отравлении антифризом).

| 
|
| Рис. 37, 38. Картина острого гнойного нефрита. Просветы ряда почечных канальцев заполнены гнойным экссудатом (стрелки). Окраска: гематоксилин и эозин. Увеличение х250. | |

| 
|
| Рис. 39. В просветах ряда почечных канальцев пигментные шлаки буро-коричневого цвета (стрелки). Пигментный нефроз. Отравление уксусной кислотой. Окраска: гематоксилин и эозин. Увеличение х250. | Рис. 40. В просветах почечных канальцев кристаллы оксалатов (стрелки). Отравление этиленгликолем (антифризом). Окраска: гематоксилин и эозин. Увеличение х400. |
Date: 2015-07-01; view: 1641; Нарушение авторских прав